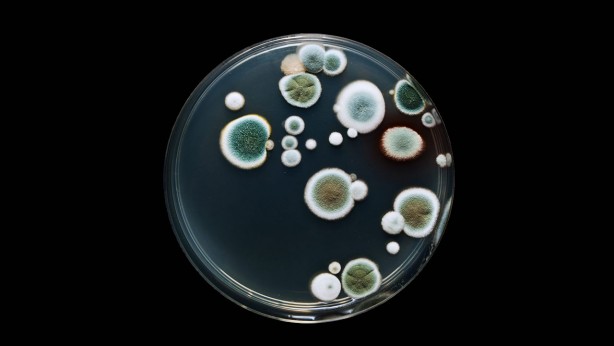
Foto - Vücudu toksinlerden arındıran 5 yiyecek

Vücudu toksinlerden arındıran 5 yiyecek
Vücudu temizleyip toksinlerden arındırmak için sıraladığımız bu 5 yiyecek birebir.
Vücudu temizleyip toksinlerden arındırmak için sıraladığımız bu 5 yiyecek birebir.
Toksin, vücudun metabolik süreçlerinin atık ürünleri anlamına gelir. Ancak bunun dışında, örneğin yanlış beslenme veya çevre kirliliği (dış kaynaklı toksinler) nedeniyle atıklar dışarıdan gelebilir.
Vücut karaciğer, böbrekler, bağırsaklar ve deri sayesinde dışkı, idrar ve ter yoluyla atıkları ve toksinleri ortadan kaldırır. Bu organlara aşırı yüklemekten kaçınmak gerekir. Toksin birikimi karaciğeri ve böbrekleri yorabilir, metabolizmayı yavaşlatabilir ve vitamin ve mineral emilimini zorlaştırabilir.
Vücutta toksin birikimi şu belirtilerle kendini gösterir: - Şişkinlik, - Yorgunluk, - Baş ağrısı, - Sindirim sorunları, - Deri döküntüleri, - Donuk ten rengi, - Aşırı yağlı veya kuru cilt, - Kepek veya saç dökülmesi. Peki, toksinlerden nasıl kurtulunur?
Vücudunuzu arındırın Vücudunuzu doğal yollarla temizleyebileceğinizi biliyor muydunuz? Öncelikle yanlış efsanelere ve mucize vadeden detoks gıdalarına dikkat edin. Mucizevi detoks gıdaları olmamasına rağmen böbrek ve karaciğer yorgunluğunu önlemek için sağlıklı besinler vardır ve vücudun arındırıcı etkisini destekleyebilir.
Bu nedenle beslenmenize bu gıdalara mutlaka yer verin: - Mevsim meyve ve sebzeleri, - Tam tahıllar, - Zencefil ve zerdeçal gibi antioksidan özelliği olan baharatlar, - Keten tohumu gibi yağ asitleri bakımından zengin tohumlar. Sindirimi destekleyen bitkiler de toksin birikimine karşı mükemmel yardımcılardır. Örneğin sindirimi destekleyen limon balsamı ve mide sularının salgılanmasını uyaran ve uygun sindirimi destekleyen safran kullanımı vücuttaki toksin birikimini azaltmaya yardımcı olur. Yeterli sıvı alımı da çok önemlidir. Su, bitki çayları ve çay tercih edilmelidir, bunu haricinde limonlu su da tüketilebilir.
Kızarmış yiyecekler, fast food ve genel olarak rafine şekerleri yüksek işlenmiş yiyeceklerden kaçınılmalıdır. Alkol gerçek bir toksindir. Vücuda besin sağlamadan karaciğer tarafından atılır. Bu, alkolün yalnızca karaciğerin doğal detoks işlevini yavaşlattığı ve aşırı tüketim durumunda karaciğere aşırı yüklendiği anlamına gelir.
Toksinlerden kurtulmanıza yardımcı olacak 5 yiyecek Bazı besinler detoks sürecini hızlandırabilir ve bu sürecin daha iyi işlemesini sağlar. İşte toksinleri vücuttan atan 5 yiyecek.
Rezene Rezene, su bakımından zengindir ve aynı zamanda arındırıcı ve idrar söktürücü özelliklere sahiptir. Sindirimi ve karaciğer fonksiyonunu uyarır, toksinleri yok etmek için mükemmel bir besindir. Sıcak veya soğuk olarak içebileceğiniz rezene ile mükemmel bir detoks bitki çayı veya rezene salatası yapabilirsiniz.
Elma Elma da idrar söktürücü besinler arasında yer alır ve vücuttaki toksinleri atmamıza yardımcı olur. Ek olarak, kolesterol kontrolünü destekleyen ve bağırsak sağlığını iyileştiren pektin içerirler.
Zencefil Zencefil, iltihap önleyici ve antibakteriyel özelliklere sahip mükemmel bir arındırıcı besindir. Metabolizmayı hızlandırır, önemli besinlerin emilimine ve atıkların ortadan kaldırılmasına yardımcı olur. Zencefil ve limon ile harika bir detoks çayı yapabilirsiniz. Lif ve su içeriği de yüksek olan limon, zencefil ve salatalık ile de harika bir detoks suyu yapabilirsiniz.
Havuç Havuç, toksinleri yok etmek için mükemmeldir. Karaciğerin işleyişini destekler ve doğal detoks işlevine yardımcı olur. Atıştırmalık olarak veya meyve suyu olarak tüketilebilirler.
Mercimek Mercimek, şişkinlikle savaşmak, vücudu arındırmak ve toksinleri atmak için mükemmeldir. Yüksek lif içeriği ile bağırsak yolunu arındırır ve detoks sürecini tetikler.
WhatsApp İhbar Hattı
+90 (553) 313 94 23